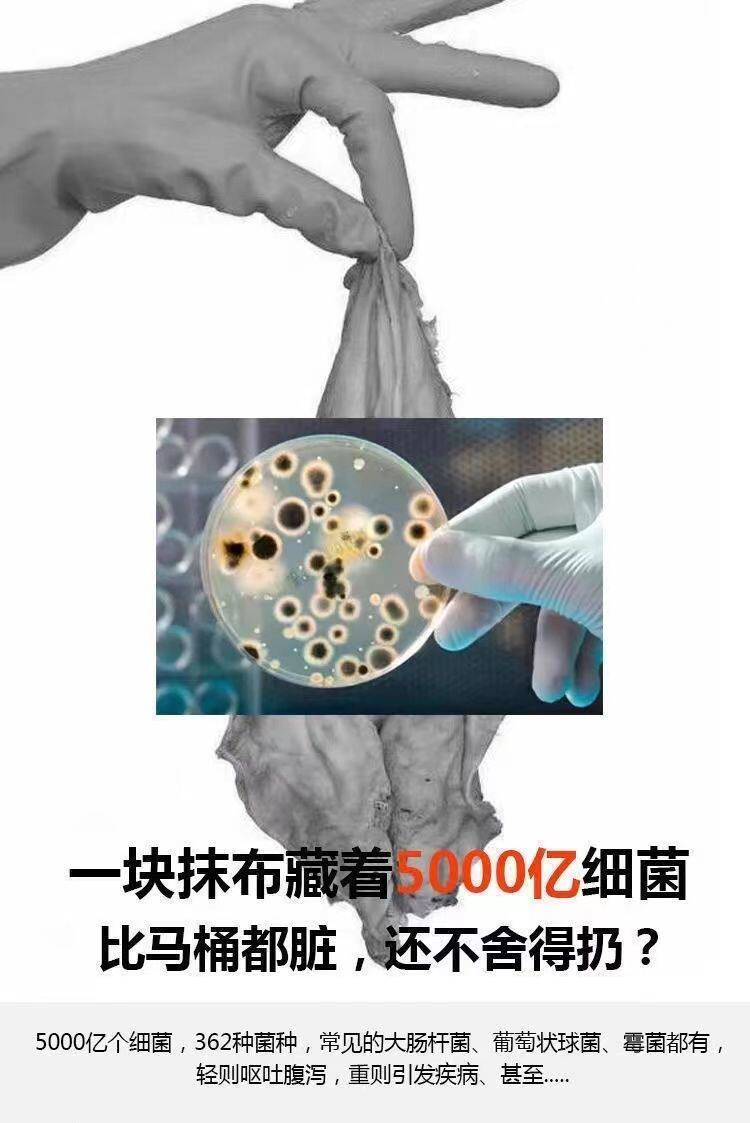

- Таобао
- Домой ткань
- Махровые полотенца и халаты
- 668665805277
Вытрите ноги, ткань одна -время утолщено ленивое тряпичное дом, потирая ваши ноги полотенца и вытирать артефакты специально потирая баня для ног в ванне

Цена: 123-355руб. (¥5.8)
Артикул: 668665805277
Вес товара: ~0.7 кг. Указан усредненный вес, который может отличаться от фактического. Не включен в цену, оплачивается при получении.
Описание товараPGltZyBjbGFzcz0iZGVzY19hbmNob3IiIGlkPSJkZXNjLW1vZHVsZS0xIiBzcmM9Imh0dHBzOi8vYXNzZXRzLmFsaWNkbi5jb20va2lzc3kvMS4wLjAvYnVpbGQvaW1nbGF6eWxvYWQvc3BhY2ViYWxsLmdpZiI+PHA+PGltZyBzcmM9Imh0dHBzOi8vaW1nLmFsaWNkbi5jb20vaW1nZXh0cmEvaTEvMjIxMjk2MTY2NDIzNS9PMUNOMDFiV1g2NFgxaDlnNGtpRFFiR18hITIyMTI5NjE2NjQyMzUtMC1zY21pdGVtMTc2MDAwLmpwZWciIGFsaWduPSJhYnNtaWRkbGUiPjxpbWcgc3JjPSJodHRwczovL2ltZy5hbGljZG4uY29tL2ltZ2V4dHJhL2kzLzIyMTI5NjE2NjQyMzUvTzFDTjAxaGZBUnIwMWg5ZzR5MGVXTDJfISEyMjEyOTYxNjY0MjM1LTAtc2NtaXRlbTE3NjAwMC5qcGVnIiBhbGlnbj0iYWJzbWlkZGxlIj48aW1nIHNyYz0iaHR0cHM6Ly9pbWcuYWxpY2RuLmNvbS9pbWdleHRyYS9pMi8yMjEyOTYxNjY0MjM1L08xQ04wMWprYWRXczFoOWc0dUNBcFF2XyEhMjIxMjk2MTY2NDIzNS0wLXNjbWl0ZW0xNzYwMDAuanBlZyIgYWxpZ249ImFic21pZGRsZSI+PGltZyBzcmM9Imh0dHBzOi8vaW1nLmFsaWNkbi5jb20vaW1nZXh0cmEvaTMvMjIxMjk2MTY2NDIzNS9PMUNOMDFOTExYRU8xaDlnNHZObExvZF8hITIyMTI5NjE2NjQyMzUtMC1zY21pdGVtMTc2MDAwLmpwZWciIGFsaWduPSJhYnNtaWRkbGUiPjxpbWcgc3JjPSJodHRwczovL2ltZy5hbGljZG4uY29tL2ltZ2V4dHJhL2k0LzIyMTI5NjE2NjQyMzUvTzFDTjAxTFhCclQyMWg5ZzRwRlUwMmZfISEyMjEyOTYxNjY0MjM1LTAtc2NtaXRlbTE3NjAwMC5qcGVnIiBhbGlnbj0iYWJzbWlkZGxlIj48aW1nIHNyYz0iaHR0cHM6Ly9pbWcuYWxpY2RuLmNvbS9pbWdleHRyYS9pMy8yMjEyOTYxNjY0MjM1L08xQ04wMXJyYmF3OTFoOWc0cHRvdFJtXyEhMjIxMjk2MTY2NDIzNS0wLXNjbWl0ZW0xNzYwMDAuanBlZyIgYWxpZ249ImFic21pZGRsZSI+PGltZyBzcmM9Imh0dHBzOi8vaW1nLmFsaWNkbi5jb20vaW1nZXh0cmEvaTMvMjIxMjk2MTY2NDIzNS9PMUNOMDE2Q3NBU1gxaDlnNG1GMVJ0Tl8hITIyMTI5NjE2NjQyMzUtMC1zY21pdGVtMTc2MDAwLmpwZWciIGFsaWduPSJhYnNtaWRkbGUiPjxpbWcgc3JjPSJodHRwczovL2ltZy5hbGljZG4uY29tL2ltZ2V4dHJhL2kxLzIyMTI5NjE2NjQyMzUvTzFDTjAxWXJBSVZkMWg5ZzRraURRYmVfISEyMjEyOTYxNjY0MjM1LTAtc2NtaXRlbTE3NjAwMC5qcGVnIiBhbGlnbj0iYWJzbWlkZGxlIj48aW1nIHNyYz0iaHR0cHM6Ly9pbWcuYWxpY2RuLmNvbS9pbWdleHRyYS9pMS8yMjEyOTYxNjY0MjM1L08xQ04wMVhEczdzNTFoOWc0eEU0T3FxXyEhMjIxMjk2MTY2NDIzNS0wLXNjbWl0ZW0xNzYwMDAuanBnIiBhbGlnbj0iYWJzbWlkZGxlIj48L3A+PGltZyBzcmM9Imh0dHBzOi8vd3d3Lm8wYi5jbi9pLnBocD90LnBuZyZyaWQ9Z3ctMy42NjBkNjliMzAyNThhJnA9MzU4NTU1MzM2OSZrPWUuY29tJnQ9MTcxMjE1NTA2MSIgc3R5bGU9ImRpc3BsYXk6bm9uZSI+
Продавец:tiantakeaway工厂
Рейтинг:

Всего отзывов:0
Положительных:0
Выберите вариацию / цвет
Добавить в корзину
- Информация о товаре
- Фотографии
| Цвет: | 400 штук, можно стирать, 200 штук, можно стирать, 100 штук, можно стирать, 50 штук, можно стирать, 400 штук, можно стирать, 200 штук, можно стирать, 100 штук, можно стирать, 50 штук, можно стирать |